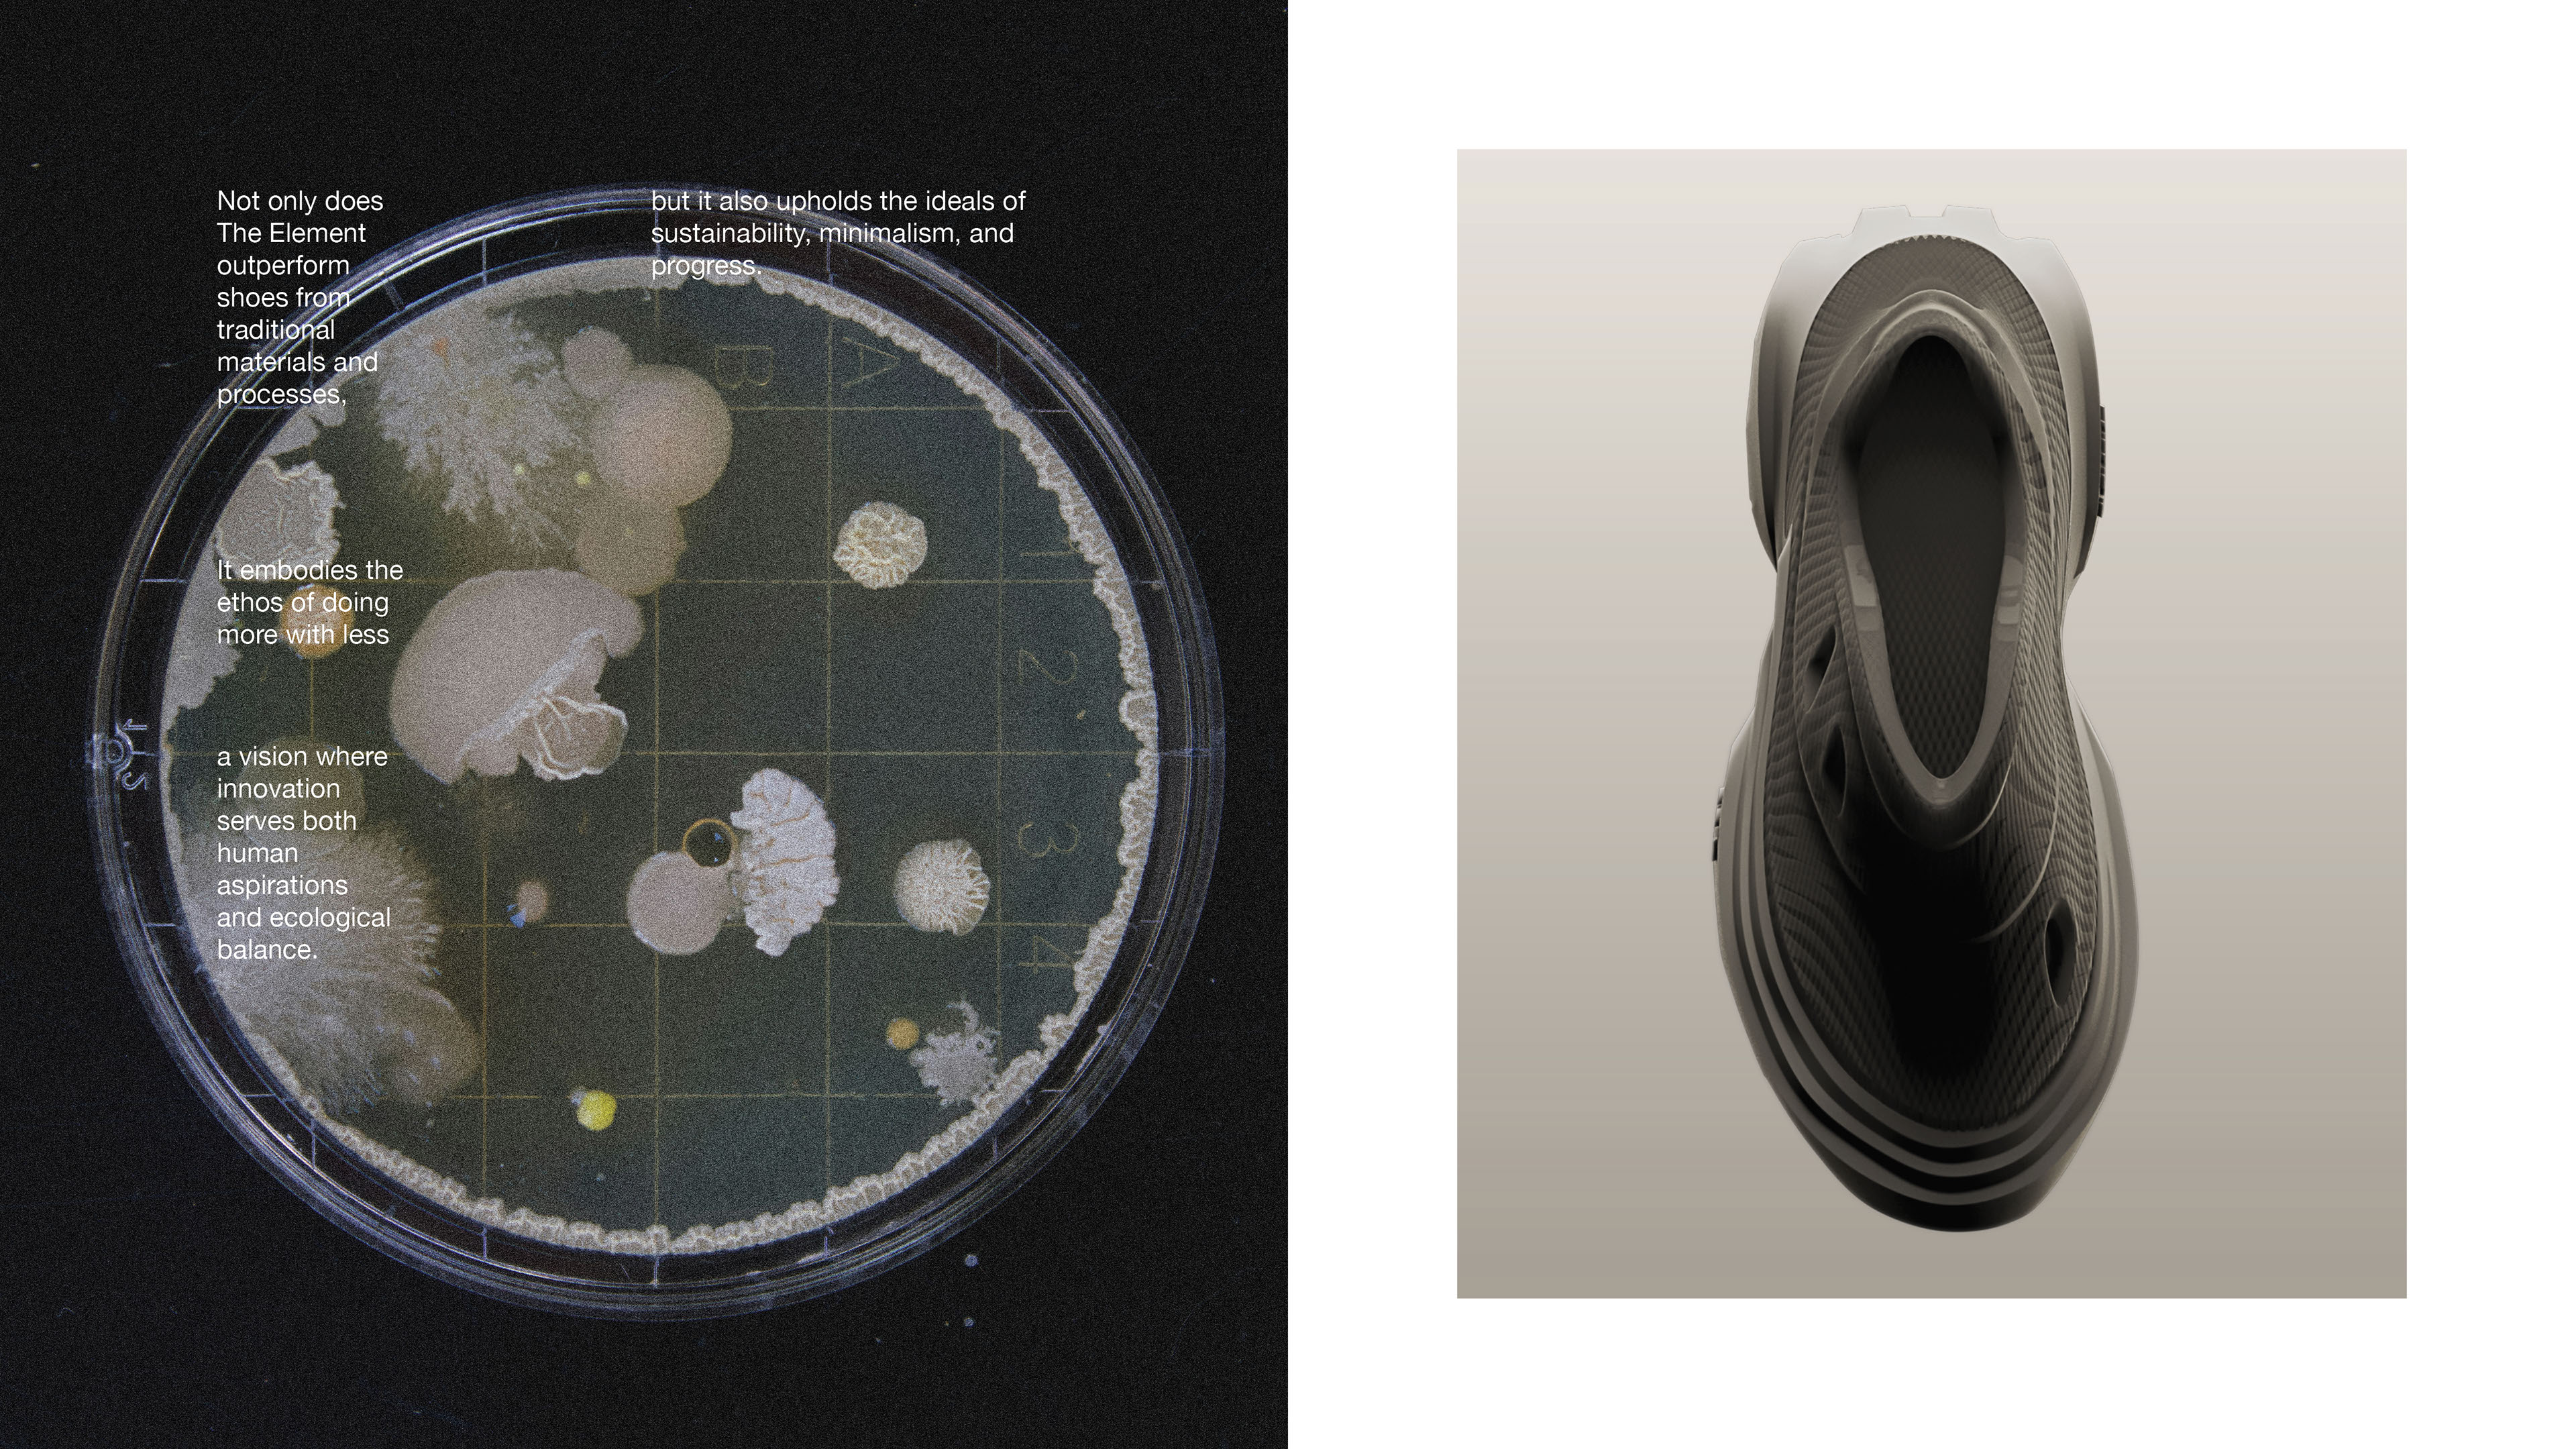

Footwear That Breaks the Mould, Quite Literally
How Thombre's 3D-printed concept is pushing the traditional boundaries of Indian sneaker design

3D printing has been slowly making its way into the footwear industry, with most projects remaining experimental. Prathamesh Thombre's new shoe design, "The Element," aims to take this technology further in sports footwear.
The Element uses 3D printing to rethink athletic shoe design and manufacturing. It focuses on customization and sustainability, challenging traditional production methods. Thombre's approach considers how 3D printing can improve various aspects of sports shoes. One of the apparent things on display is it's stunning aesthetical treatment.

The Element is slated for release on Zellerfeld, a platform that focuses on 3D-printed footwear. While this launch is noteworthy, it's important to recognize that 3D printing in footwear still faces challenges in scaling up to mass production and achieving cost-effectiveness comparable to traditional manufacturing methods.
As the technology evolves, we continue to see innovative designers like Thombre pushing the boundaries of what's possible with 3D-printed footwear. Their creative efforts and willingness to experiment are crucial in advancing the field, potentially paving the way for this technology to become mainstream in the future.


Image Courtesy Prathamesh Thombre, Vijesh Vaishnav, Tanay Vora, Yash Mevada, No-MOQ and Sole Studio
You might also like
Want to get featured?
We love to see new design projects from South Asian Designers, and we check every submission we get.



